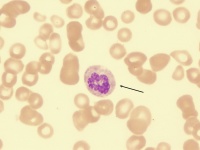

恶性贫血
恶性贫血又称为巨幼红细胞性贫血,在我国比较少见,病因常由妊娠、哺乳、胃吸收不良、营养不良或口服叶酸拮抗药(具有拮抗二氢叶酸合成酶,使四氢叶酸合成发生障碍的药,如乙氨嘧啶、甲氨蝶呤)所致。
基本概述[编辑 | 编辑源代码]
恶性贫血属于核成熟障碍型贫血三组中的一组,国内少见,本病的基本缺陷在于胃内因子分泌障碍。胃内因子产生于胃体和胃底,这是一种胃粘蛋白,有加速维生素B12在小肠粘膜吸收的作用。因此本病患者存在维生素B12吸收障碍,产生维生素B12的相关临床表现。胃内因子缺乏的发病机制尚待阐明,可能与遗传或自身免疫因素有关。
良性贫血有别于恶性贫血,前者是由于缺铁,使血红蛋白(血色素)合成减少,但红细胞不低;后者是缺乏叶酸和维生素B12等造血因子,使幼稚红细胞在发育中的脱氧核糖核酸(DNA)合成出现障碍,细胞的分裂受阻,形成畸形的巨幼红细胞,并伴有神经症状(神经炎、神经萎缩)。
病因[编辑 | 编辑源代码]
恶性贫血的基本缺陷是因胃粘膜永久性的萎缩,不能分泌内因子。由于缺乏内因子,食物中的维生素B12不能被吸收。
这种胃粘膜萎缩,一般指慢性萎缩性胃炎,范围广泛,而在胃的体部最显著,在胃窦部改变较少。胃粘膜萎缩处有大量淋巴细胞和浆细胞浸润。组织学切片显示主细胞和壁细胞几乎完全消失,常常变成象小肠的上皮细胞。由于这些细胞的萎缩,内因子及盐酸的分泌均不存在,胃蛋白酶的分泌显著减少。注射组织胺或胃泌素也不能使胃液中出现盐酸。尿中尿胃蛋白酶的排泄显著减少。血液中胃泌素的浓度增高。
恶性贫血的发病机理目前多认为是遗传因素和自体免疫因素复杂的相互作用的结果。
遗传因素:恶性贫血的发生与种族和遗传显然有关。诸如①本病最多见于北欧的斯堪的那维亚人,特别是瑞典中部的人;②恶性贫血患者血型属于A型者比其他型者多;③约有10%病人,其同一代或不同代的家族中患有同病者超过1人;在家族中有血清维生素B12浓度低于正常,血清或胃液中有自抗体及患有其他自体免疫疾病的发病数都比一般人高。
自体免疫因素:恶性贫血病人同时患有其他自体免疫疾病,如甲状腺机能亢进、甲状腺机能减退及桥本氏甲状腺炎者较多见。很多患者的血清及胃液中可查出胃的自抗体,如壁细胞抗体,内因子抗体,抗内因子抗体等,这些抗体可直接引起胃粘膜萎缩和维生素B12吸收障碍。
临床表现[编辑 | 编辑源代码]
典型病例有下列三组特征:
①巨幼细胞性贫血;
③周围神经变性与脊髓联合变性。神经系统症状主要有:周围神经变性引起肢体麻木感或感觉异常;脊髓后索变性引起腱反射消失,肌张力减弱,位置觉紊乱;反射亢进与肌张力增强等。神经系统症状可为本病的突出表现,甚至病人被疑为周围神经炎或多发性硬化而首先就诊于神经科。
血象出现巨红细胞,骨髓显示巨幼红细胞增生。胃酸缺乏,空腹血清胃泌素显著增高。有条件可检测内因子及其抗体。
诊断[编辑 | 编辑源代码]
本病的诊断一般可根据临床特征、血象与骨髓象、胃液分析、维生素B12的疗效以及长期随诊而确定。血清维生素B12测定、放射性核素维生素B12吸收试验也有助诊断。
首先应与红血病相鉴别,后者用维生素B12治疗无效,且幼稚红细胞形态有明显的病理改变。在再发期病例常有溶血现象,应注意与其他类型溶血性贫血相区别。病人有食欲减退、胃游离盐酸缺乏,尚需与胃癌相区别;但须注意,本病可为胃癌的前期。
国产维生素B12疗效常不显著,常用弥可保,再者针灸治疗能明显改善下肢无力症状。
治疗[编辑 | 编辑源代码]
对由营养不良、婴儿期、妊娠期的恶性贫血患者,可选用叶酸治疗,成人1次~10mg,儿童1次mg,1日3次,同时辅以维生素B12肌内注射1次~1.5mg,口服每日~4.5mg。对药物引发的贫血,合并应用甲酰四氢叶酸钙静滴治疗,1次mg,1日1次。
护理要点[编辑 | 编辑源代码]
给病人富于营养和高热量、高蛋白、多维生素、含丰富无机盐和饮食,以助于恢复造血功能。
缺铁性贫血可多吃动物的内脏,如心、肝、肾以及牛肉、鸡蛋黄、大豆、菠菜、红枣、黑木耳等。
巨幼红细胞性贫血在疗程后期可能出现相对缺铁现象,要注意及时补充铁剂。
再生障碍性贫血患者要注意防止交叉感染,尽量不要去公共场所。住房要通风。忌服合霉素、氯霉素、磺胺类、退热止痛片等抑制骨髓的药物。
避免过度劳累,保证睡眠时间。
相关人物[编辑 | 编辑源代码]
居里夫人是一位法国籍波兰科学家。她研究放射性现象,发现了一系列新元素,包括镭和钋。此外她的放射原理以及放射同位素分离法都是非常有名的。1903年她和丈夫皮埃尔一起荣获诺贝尔奖。当时放射性元素的破坏作用还没有被发现,居里夫人在工作时没有采取任何保护措施,有时将装有放射性元素的试验管放在衣袋里,有时放在抽屉里,由于长期接触放射性元素,居里夫人最终在1934年7月4日死于恶性贫血。
| ||||||||||||||||||||||||||||||||||||||||||||||||||


